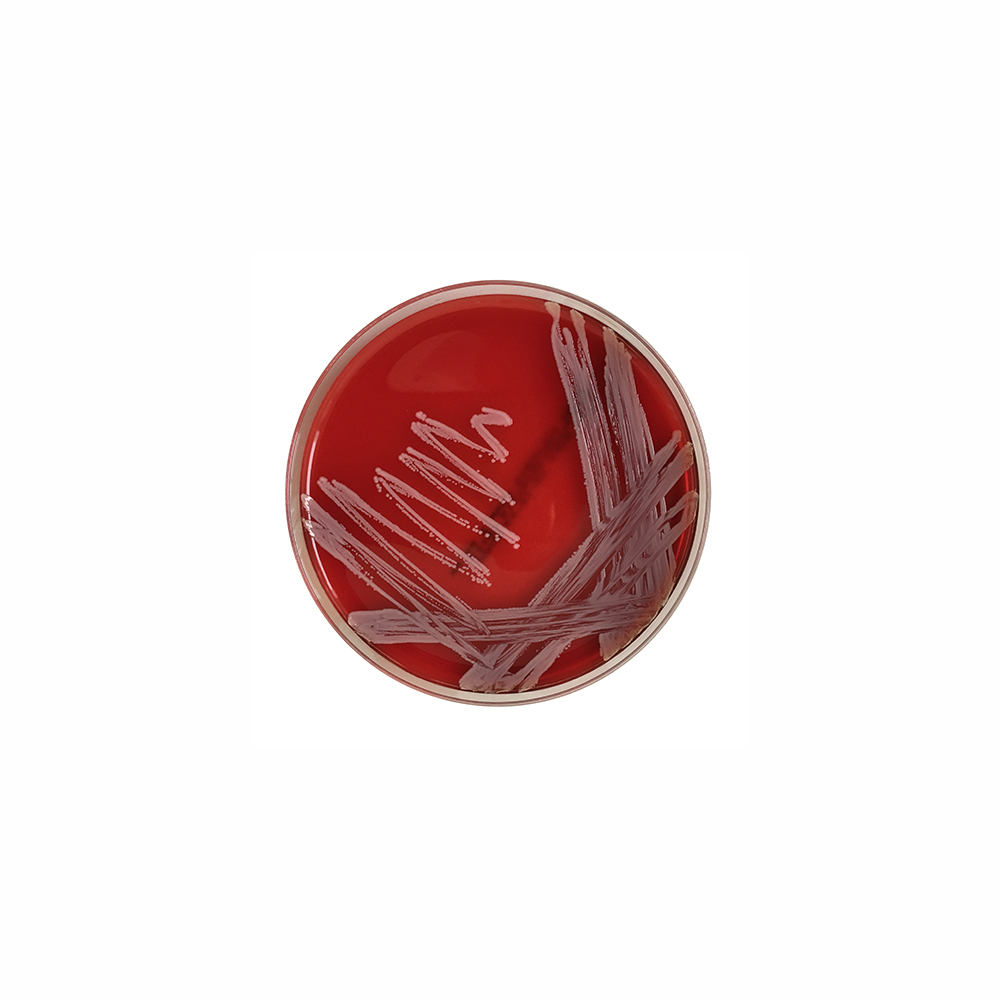

À propos du produit
La gélose Columbia + 5 % de sang de mouton est un milieu non sélectif utilisé pour la détection qualitative de bactéries fastidieuses et non fastidieuses dans des échantillons cliniques humains et d’autres échantillons. La gélose Columbia +5% Sang de mouton est le principal milieu utilisé pour les tests microbiologiques des infections causées par la plupart des agents pathogènes humains.
L’utilisation de la gélose Columbia +5 % de sang de mouton représente un support au diagnostic chez les patients présentant des symptômes indiquant des infections potentielles par divers micro-organismes pathogènes.
Les micro-organismes pathogènes humains appartiennent à divers groupes de bactéries qui provoquent des infections locales des tissus et des organes, ainsi que des infections systémiques. En raison de ses propriétés, le milieu est utilisé pour la détection de la plupart des micro-organismes pathogènes appartenant à différents groupes taxonomiques. Ces micro-organismes comprennent les cocci à Gram positif (Staphylococcus, Enterococcus, Streptococcus), les bacilles à Gram négatif (Enterobacterales, Pseudomonas, Acinetobacter), ainsi que les bacilles à Gram positif (Corynebacterium ). La présence de sang dans le milieu permet de déterminer le type d’hémolyse, qui est utilisé dans l’identification préliminaire de certains groupes de micro-organismes, en particulier les membres du genre Streptococcus.